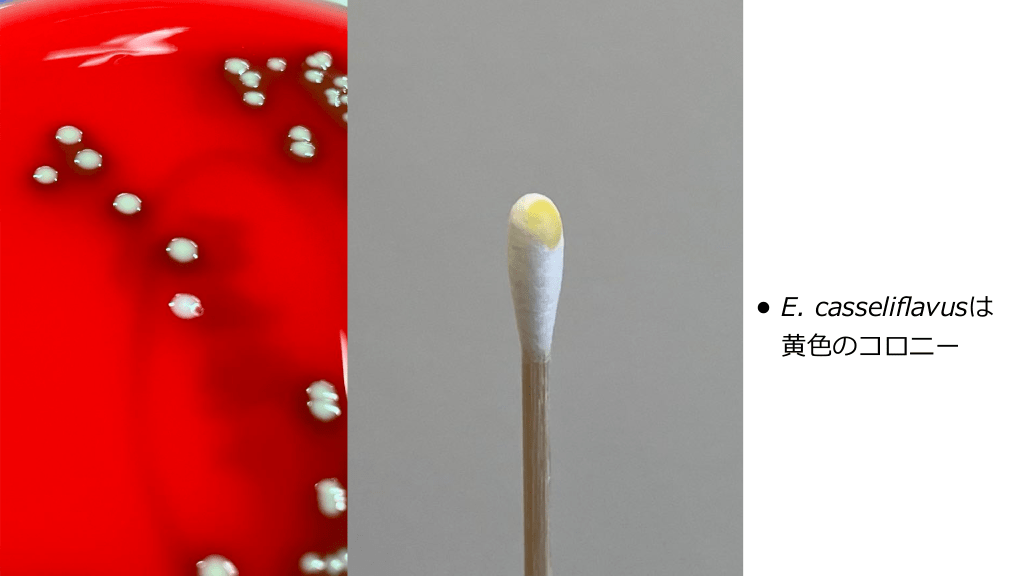

1/64
関連するスライド
感染症診療の基本的な考え方 -感受性検査結果の読み方-
高野哲史
68555
200
黄色ブドウ球菌菌血症の考え方
長谷川耕平
632485
608
経口抗菌薬のエッセンス
高野哲史
383666
1057
発熱性好中球減少症
長谷川耕平
80513
181
腸球菌感染症とその周辺
55,234
88
概要
感染症科内で行ったレクチャー資料を共有します。
1. 概論
2. 菌血症について
3. 治療と薬剤耐性 (総論・各論)
4. IEに対する抗菌薬併用について
込み入った内容になってしまっていますが興味があればどうぞ。
本スライドの対象者
医学生/研修医/専攻医/専門医
投稿された先生へ質問や勉強になったポイントをコメントしてみましょう!
0 件のコメント
長谷川耕平さんの他の投稿スライド
細菌性髄膜炎のマネジメント
長谷川耕平
103,230
206
Mpox (サル痘) のまとめ (2023.04.19更新)
長谷川耕平
21,920
68
皮膚軟部組織感染症 overview
長谷川耕平
319,216
622
このスライドと同じ診療科のスライド
テキスト全文
腸球菌感染症の症例紹介と治療方針
#1.
2025.01.16 腸球菌感染症とその周辺 谷 長 立 堺市 総合医療センター 感染症内科 川耕平
#2.
• 63歳男性, LVFX内服で改善しない熱が14 • 既往歴:5年前に 動脈弁閉鎖不全症に対して機械弁置換術 • 採 間続くため受診 特記なし, CXR著変なし :WBC 10,300/μL, Cre 1.3 mg/dL, CRP 12 mg/dL 液培養:3set E. faecalis (ABPC-S, AG-high level resistance) 日 見 • 体所 大 • 血 身 血 CASE ①
#3.
• 83歳男性, 結腸穿孔に伴う汎発性腹膜炎に対して洗浄ドレナージ, • 既往歴:直腸癌術後, CKD, COPD • ショックバイタルでICU 室, MEPM投与開始 • 腹 門 工 人 では, GPC chain, GNR, GPR 入 グラム染 色 水 CASE ② 肛 造設
#4.
• 80歳 性, 後腹膜線維症による尿管狭窄に対しD-J stent留置されている • 尿路感染による敗 • MEPMが開始され, 速やかにD-J stent交換 症性ショックでICU 室 入 培からK. pneumoniae, 尿・腎盂尿培養からK. pneumoniae, E. faecalis 血 • 女 血 CASE ③
腸球菌の特徴と薬剤耐性について
#5.
概論 • 菌 • 治療と薬剤耐性 (総論, 各論) • IEに対する抗菌薬併 について 症 用 血 •
#6.
Enterococcus spp. • γまたはα溶 , Lance eld D群, PYR陽性, 胆汁エスクリン分解, LAP陽性, 6.5%NaCl存 在下で発育する, 壌, 淡 , 海 からも分離され, 植物や発酵 品, 脊椎動物および無脊 椎動物の腸内細菌叢の 部, ヒトでの病原菌として分離されるグラム陽性連鎖球菌1-2) • ヒトではE. faecalisとE. faeciumがほとんどで, 1-17%でその他のEnterococcus spp. (E. casseli avusなど) が検出される3) • グラム染 上, E. faecalis→肺炎球菌に似たランセット型双球菌, E. faecium→落花 サ インが参考となるがわからないことも多い。また, Enterococcus spp.は分裂する側の先 端が尖って えることがある4-5) 1. Mandell, Douglas, and Bennett's Principles and Practice of 生 食 水 水 色 一 fi 立 土 血 見 fl 色 田 2. 3. 4. 5. Infectious Diseases, 200, 2492-2504.e4 Clin Microbiol Rev. 2019;32(2):e00058-18. Open Forum Infect Dis. 2024;11(6):ofae288. 感染症学雑誌 2019;93:306-311 永 邦昭著, 第3版 感染症診断に役 つグラム染
腸球菌の分離と感染症のリスク因子
#7.
E. faecalis E. faecium
#8.
E. faecalis E. faecium E. faecium 血 E. faeciumはうっ すらα溶 する
#9.
fl 色 黄 • E. casseli avusは のコロニー
#10.
当初“enterococcus”は消化管から分離されたグラム陽性 球菌を指す単語だったが, 1970年頃からEnterococcus spp.とすべきという意 が出始め, 1986年に登録された 見 Timeline of relevant events in the history of enterococci as human pathogens (blue rectangles), appearance of antibiotic resistance (green rectangles), and antibiotic clinical debut (red rectangles). Clin Microbiol Rev. 2019;32(2):e00058-18.
#11.
Mannitol Sorbose Arginine Arabinose Tellurite 運動性 素産 E. faecalis + ー + ー + ー ー E. faecium + ー + + ー ー ー E. casseli avus + ー + + ー + + E. gallinarum + ー + + ー + ー E. avium + + ー + ー ー ー E. ra nosus + + ー + ー ー ー 生 fl ffi 色 Manual of Clinical Microbiology 11th Edition, p.410より作成 色 黄 Enterococcus spp.
#12.
• ヒトの消化管ではE. faeciumとE. faecalis が最も多く分離される • 豚, 家禽, が優勢 • E. gallinarum, E. cecorum, E. durans, E. aviumなどもproduction animalから検 出される • 環境では, E. mundtiiとE. casseli avusが 主に植物から検出される などの消化管ではE. faecium fl 牛 Clin Microbiol Rev. 2024;37(2):e0012123.
腸球菌感染症の診断と治療の考え方
#13.
Enterococcus spp. • S. pyogenes, S. pneumoniae, S. aureusなど他 のGPCより病原性が低いとされている1) • Enterococcus spp.は腹腔Mφに貪 されても72時 間まで 存できるため, 腸管で増殖した場合に単純 確率で 流播種の可能性が くなる2) • 各種感染症を引き起こす重要な病原因 イオフィルム形成が挙げられる3) として, バ 子 食 高 血 生 1. Clin Infect Dis. 2024;78(1):e1-e11. 2. Microbiol Spectr. 2019;7(4):10.1128/microbiolspec.gpp3-0053-2018 3. Virulence. 2017;8(8):1525-1562.
#14.
多様な複数菌感染部位における腸球菌の多 的役割 面 Trends Microbiol. 2024;32(2):162-177.
#15.
• 尿培養から検出された場合に 概に治療すべきかは議論が分かれるが, Enterococcus spp.は成 のcUTIにおいて初期治療失敗+ 院期間延 と関連しており3), 治療対象とし た がよい場合があることは確からしい • 個 的には, 閉塞性UTIや が多い 管内デバイス (IE risk) がある場合など治療対象とすること 皮 皮 長 1. J Infect Chemother. 2024;30(7):579-589. 2. Microbiol Spectr. 2019;7(4):10.1128/microbiolspec.gpp3-0053-2018 3. Infection. Published online August 28, 2024. DOI: 10.1007/s15010-024-02372-0 入 一 in vitroでは, E. faecalisのバイオフィルム形成に関連するEspは膀胱上 に対して組織特 異性を有し, plasmidにcodeされたaggregation substanceが腎上 細胞に, Ebpにcode される繊 は尿路上 やカテーテルへの接着に重要である2) 血 • 皮 本のサーベイランスデータで, cUTI患者の16.4%からE. faecalisが分離されている (膀 胱留置カテーテル, 腎瘻, 膀胱瘻, 尿路変更術は除外)1) 毛 • 人 人 方 日 尿検体でのEnterococcus spp.
#16.
腹腔検体でのEnterococcus spp. • 市中発症の腹腔感染症に対し, 経験的Enterococcus spp.カバーによる転機の差は認めら れていない1) • 免疫不全, 術後腹膜炎, セファロスポリンなどのEnterococcus spp.をカバーしない広域 抗菌薬を使 している場合, 弁や 管内デバイスが留置されている場合, 重症敗 症 は予後不良群とされており経験的Enterococcus spp.カバーを検討する2) • Enterococcus spp.感染が確認された患者 (特にHA-IAIs) では死亡率が有意に上昇する3) が, Enterococcus spp.に活性のある抗菌薬を投与することによる死亡率の低下は認めら れていない4) • 最近の報告ではEnterococcus spp.がその他の細菌と協調し病原性を悪化させる可能性も 1. Clin Infect Dis. 2010;51(6):757-759. 指摘されており, 治療対象とした が良いとする意 もある5) 2. Br J Surg. 2002;89(3):361-367. 3. Clin Infect Dis. 2010;50(2):133-164. 血 見 血 方 工 人 用 4. J Antimicrob Chemother. 2002;50(4):569-576. 5. Trends Microbiol. 2024;32(2):162-177.
Enterococcal Bacteremiaの疫学と治療
#17.
概論 • 菌 • 治療と薬剤耐性 (総論, 各論) • IEに対する抗菌薬併 について 症 用 血 •
#18.
• 腸球菌菌 症 (EB, Enterococcal bacteremia) は, の患者によくみられる1) • EBは死亡率が く (〜20%), 患者の基礎状態, 併存疾患, IEなどの合併症, 薬剤耐性, ICU 室の必要性など, 様々なリスク因 に強く影響される2-3) 齢者, 衰弱した患者, 免疫抑制状態 高 子 高 1. Nat Rev Microbiol. 2012;10(4):266-278. 2. Clin Microbiol Infect. 2011;17(7):1078-1083. 3. Int J Infect Dis. 2014;26:76-82. 血 入 Enterococcal Bacteremia (EB)
#19.
Enterococcal Bacteremia (EB) • E. faecalis菌 症はenterococcal IEの90%以上, 泌尿 連がより 般的 - E. faecalis IEは 殖器の異常 (CAUTI含) との関 腸病変 (腺腫や癌) と関連があるかもしれない E. faecium菌 症は消化管や との関連がより多い • E. casseli avus (E. avescens含), E. gallinarumは胆道系感染での検出が多い 管内カテーテル, 過去の広域抗菌薬使 , 移植, 肝硬変症 用 生 血 fl 大 血 血 Nat Rev Microbiol. 2012;10(4):266-278. Mayo Clin Proc. 2021;96(1):132-146. Clin Microbiol Infect. 2011;17(7):1078-1083. Int J Infect Dis. 2014;26:76-82. Clin Microbiol Infect. 2014;20(2):145-151. Clin Infect Dis. 2004;38(1):53-61. Infect Drug Resist. 2023;16:363-368. fl 一 •
#20.
生 血 Enterococcal Bacteremia (EB) Focus 原発性 管内デバイス 腹腔 殖器・尿路 SSTI rate (%) All E. faecalis E. faecium 22 23 20 15 17 10 41 30 61 27 36 9 5 5 6 Clin Microbiol Infect. 2021;27(3):364-371.より作成
腸球菌感染症のワークアップと治療戦略
#21.
• 広域抗菌薬使 • 腸球菌の定着や感染の既往 • 泌尿 • 尿路または消化管に関わる • 下での院内感染 (ex. セファロスポリン) 殖器および腹腔臓器に関連する併存疾患 (LC, 移植など), 悪性疾患 (固形/ 液) 術 (肝胆道を含む) 管内デバイスおよび/または膀胱留置カテーテル 血 子 手 用 Arch Intern Med. 1993;153(13):1581-1586. Clin Microbiol Infect. 2021;27(3):364-371. 生 血 EBのリスク因
#22.
ワークアップ • 菌 症のfocus検索 (ルート刺 部, 合併症を特定するための 体診察 • 疑わしいfocusの培養:尿, 胆汁液, 腹 • 疑わしいfocusの画像精査:泌尿 殖器および肝胆道のエコー, 腹部CT, 視鏡検査, 18FDG PET-CT (ex. グラフト感染) など 雑 , 腹部, , 膿瘍, 術創等), 塞栓, 膿瘍, 髄炎などの 術創深部の検体 エコー, 腸内 大 骨 心 手 手 音 水 心 生 入 身 血 Clin Microbiol Infect. 2021;27(3):364-371.
#23.
1セットのみから発育した場合 • 明らかなfocusがなくEnterococcus spp.が 液培養1セットのみから検出された場合, コ ンタミネーションの可能性が11-17%ある1-2) • カテーテルハブへの定着も起こりうるため, 逆 • 発育したセット数が1セットと2セットで臨床転機は変わらず, 1セットでも真の菌 して治療した がいいとする意 もある4) での培養採取でも混 しうる3) 症と → 管内デバイスの有無などにも左右されるためクリアカットに分けることは難しく個別 判断を要するが, 未治療ならば 液培養の再検は必須である 1. Am J Med. 2010;123(9):819-828. 2. Am J Infect Control. 2011;39(5):436-438. 血 入 血 血 見 血 方 血 3. Clin Microbiol Rev. 2019;33(1):e00009-19. 4. Eur J Clin Microbiol Infect Dis. 2014;33(11):1995-2003.
#24.
- 塞栓症状がある菌 - - IE riskがなければ経過観察 - - IE riskが1-2あれば検討 - focus不明 - IE riskが≧3あれば - 市中発症 症の再燃時 う 弁, 既知の弁膜症, IEの既往 - 雑 - 単 - 1週間以上続く症状 菌による菌 症 Clin Microbiol Infect. 2021;27(3):364-371. 管内デバイスがなく, 速やかに解熱している場合以外は推奨している 行 血 行 血 血 血 血 血 血 培≧2setからE. faecalis発育 培フォローの閾値はもう少し低くしており, focusがドレナージされているUTI/胆管 血 的には 炎かつ弁膜症・ 音 症や菌 E. faeciumを始めE. faecalis以外のEnterococcus spp.菌 症に対しては, 菌 症再燃, 弁膜症による 不全徴候, 塞栓症, 管内デバイスなどがある場 合に う 個 行 工 一 • 表. IEに関連したリスク因 子 • うか? E. faecalis菌 症に対する適応 (右表) 血 • 人 心 人 血 心 心 エコーはいつ
腸球菌に対する抗菌薬の感受性と耐性機序
#25.
E. faecalis IEの特徴 • NVEよりも, PVEで起因菌となる頻度が PVEで最も多い1) • non-enterococcal IEと 較し, 齢, 慢性肺疾患, CHF, IE既往, 変性性弁疾患が多く, 罹 患部位として 動脈弁と 弁に多く, PM/ICDは稀で, 急性 不全を呈しやすい2) • E. faecalis IEのTTP (time to blood culture positivity) は, E. faecalis菌 症全体に対 し有意に短く (median 9.4h vs 11.6h), ロジスティック解析では, TTP ≦ 12hはIEと関 連していることが された3) く, Enterococcus spp.内で 較するとTAVI- 1. Clin Infect Dis. 2023;77(12):1617-1625. 血 比 心 高 高 工 人 比 示 大 2. J Am Coll Cardiol. 2020;75(5):482-494. 3. Eur J Clin Microbiol Infect Dis. 2021;40(8):1657-1664.
#26.
腸球菌に対するNOVA・DENOVA adapted NOVA1) 項 Number of positive cultures ≥ 2 (N) Unknown origin of bacteremia (O) Prior valve disease (V) Auscultation of a heart murmur (A) DENOVA2) 項 Pts 5 4 2 1 ≧4点でIEに対する感度97%・特異度23% Pt Duration of symptoms ≥ 7 days 1 Embolization 1 Number of positive cultures ≥ 2 1 Origin of infection unknown 1 Valve disease 1 Auscultation of murmur 1 ≧3点でIEに対する感度100%・特異度83% 目 目 1. Clin Infect Dis. 2016;63:771 2. Infection. 2019;47(1):45-50.
#27.
概論 • 菌 • 治療と薬剤耐性 (総論, 各論) • IEに対する抗菌薬併 について 症 用 血 •
#28.
感受性 ABPC IPM VCM TEIC LZD DAP E. faecalis S S S S S S E. faecium R R S S S SDD〜R E. casseli avus E. avescens E. gallinarum S S R S S S Other Enterococcus spp. S〜R S〜R S〜R S〜R S S fl fl ※全ての菌種でセファロスポリン, TMP-SMXとAG (低濃度) は内因性耐性 Antimicrob Agents Chemother. 1999;43(10):2542-2546. Clin Microbiol Rev. 2024;37(2):e0012123.
#29.
Enterococcus spp.に対するβL • Enterococcus spp.は内因性にセファロスポリン耐性を獲得しており, bPBPである Pbp5(4)との親和性の低さ, PbpA(2b)とPbp5(4)がセファロスポリン存在下で協調して ペプチドグリカンの架橋を仲介することに由来する1) • 全てのβLに対してtoleranceを有している (MBC/MIC 作 する2) が きい) ため, βLが“静菌的”に 大 比 用 1. Antimicrob Agents Chemother. 2020;64(4):e02273-19. 2. Clin Microbiol Rev. 1990;3(1):46-65.
#30.
PCN耐性機序は4つ 1. PBP5の過剰産 (βLにlow a nity) - E. faecium 2. βラクタマーゼ産 (Staphylococcus spp.由来) - E. faecalis 3. PBP5の突然変異 (Ldtfm) - E. faecium 4. PBP4の過剰産 (PCG-R, ABPC-S) - E. faecalis ffi 生 生 生 Expert Rev Anti Infect Ther. 2014;12(10):1221-1236. Microb Drug Resist. 2021;27(3):291-300.
バンコマイシン耐性腸球菌の治療法
#31.
PCG-R, ABPC-S E. faecalis • 2006年以降, PCG-R, ABPC-S (PRAS) E. faecalisが臨床分離株から報告されている • ブラジルからの報告では11%, 韓国は22.7%がPRAS J Clin Microbiol. 2022;60(9):e0084321.
#32.
PCG-R, ABPC-S E. faecalis 韓国の後 視的研究において, 295例のE. faecalis菌 ABPC-S (PRAS) 症のうち67例 (22.7%) がPCG-R, - PRASはPSASと 較し30 - PRASのABPC・PIPC治療群における死亡率は, PCG MIC≦4→13%, MIC=8→29%, MIC≧16→41.2% - ABPC・PIPC群ではPRAS vs PSASで 死亡率が かった (OR 2.27) 存率が異なるが, グリコペプチド群では差はなし PRAS-EF菌 症の治療戦略については今後の報告待ち 血 生 高 日 比 血 Antimicrob Agents Chemother. 2019;63(7):e00291-19. 方 •
#33.
E. faecalisのPIPC感受性 • Enterococcus spp.では 般にABPC-SならばPIPC-Sが予想されるため1), CLSIではβlacatamase 産 株においてPCG, ABPCの感受性結果をPIPC, PTZに外挿して良いこと になっている2) • しかし, PRAS-EFではPIPC-R 98%と報告されており3), 現 のエビデンスからABPCの感 受性をPIPCに外挿できない場合があることがわかっている • EUCASTには, 2023年までは”PIPC-Sが予想されるがABPC-RならばPIPC-R”と記載され ていたが, 2024年のupdate以降PIPCのBPを設定した (S≦0.001, R>16)4) いため, PIPC, PTZは いない がベ 方 1. Diagn Microbiol Infect Dis. 1994;20(3):143-149. 2. CLSI M100-ED34:2024 Performance Standards for Antimicrobial Susceptibility Testing, 34th Edition 3. Ann Clin Microbiol Antimicrob. 2020;19(1):43. 4. EUCAST Clinical Breakpoint Tables v. 15.0, valid from 2025-01-01 用 行 高 一 生 非 → 少なくともPRAS-EFの場合はPIPC-Rの可能性が ター (ただし臨床データは乏しい)
#34.
症に対するVCM • 後 視的研究において, E. faecalis菌 30 死亡率が同等1)〜上昇する2) • 1年後死亡率はVCM>βLで, • EBに対する経験的治療として, 結果的にPCG感受性株が検出されたとしても, VCMはβL と 較し30 死亡率を悪化させない3) • 単 症に対する標的治療としてのVCMは, βLと 長 方 血 血 較し い1) 1. J Pharm Pract. 2019;32(4):375-381. 2. J Antimicrob Chemother. 2014;69(8):2252-2257. 3. Int J Antimicrob Agents. 2019;53(6):761-766. 比 院期間もVCMの が 視的研究であり追試は必要 入 施設, 後 方 日 日 方 比 一 E. faecalis菌
#35.
• バンコマイシン耐性に関連する遺伝 (vanA, B, C, D, E, G, L, M, N)1) - vanCのみが内因性で, 他は獲得耐性 • ペプチドグリカンにおける-D-Ala5が, D-lactate (vanA, M, B)やD-serine (vanC, D, E, G, L, M, N) に置換される2) • 度グリコペプチド耐性に関連するのはvanA, Mで, vanAはトランスポゾン内にあり接合伝達 によってVRSAの発 に関連する3) 1. Infect Drug Resist. 2015;8:217-230. 2. 本臨床微 物学雑誌 2014;24;180-194. 3. Curr Opin Infect Dis. 2005;18(4):300-305. VCM MIC TEIC MIC Transfer Lacation Expression Species vanA 64-1,000 16-512 + p/c inducible E. faecium, E. faecalis vanB 4–1,000 0.5–1 + p/c inducible E. faecium, E. faecalis inducible E. casseli avus E. avescens E. gallinarum 0.5-1 ー 子 子 2-32 生 fl 生 vanC fl 高 日 van遺伝 c
#36.
の細胞表 に存在する薬剤認識の分 構造の違いにより vanAはVCM-R, TEIC-R, vanBはVCM-R, TEIC-Sとなる 子 面 白 本臨床微 生 日 センサー蛋 物学雑誌 2014;24;180-194.
腸球菌感染症におけるDAP耐性と治療戦略
#37.
胆道系感染, カテーテル感染が多く含まれたE. faecium菌 症患者において, TEICは VCMと 較し臨床転機に関して 劣勢かつ急性腎障害が少ない傾向にあった3) • E. faecalis IEに対するTEICはABPC+CTRXと に使 できる可能性が報告されている4) 較し1年間累積死亡率悪化させず, OPAT 血 1. 2. 3. 4. 血 日 • 比 TEICが臨床的にどの程度有効か した研究は少ないが, E. faecium菌 症についてTEIC とVCMとを 較した多施設サーベイランスでは, 30 死亡率に有意差は認めなかった2) 示 • 非 主にvanAによってもたらされるD-Ala-D-Ala → D-Ala-D-Lac置換ではグリコペプチド全 般のMIC上昇が じるが, vanCによるD-Ala-D-Ser置換ではTEICのMICは上昇しない1) 生 • 比 比 用 テイコプラニン Infect Drug Resist. 2015;8:217-230. Int J Infect Dis. 2022;122:506-513. J Antimicrob Chemother. 2023;78(5):1231-1240. J Antimicrob Chemother. 2024;79(11):2809-2814.
#38.
MIC breakpoint (μg/ml) S SDD I R E. faecium Enterococcus spp. (E. faecium以外) 備考 – ≦4 – ≧8 SDDのbreakpointはDAP 8-12 mg/kg q24h投与下で, E. faeciumの重症感染を対 象とする。 感染症専 医へのコンサルト推奨 ≦2 – 4 ≧8 “S”はDAP 6mg/kg q24hを元にしている CLSI M100-ED34:2024 Performance Standards for Antimicrobial Susceptibility Testing, 34th Editionより抜粋 • 2020年CLSIの改訂で, E. faeciumのDAPに対する”susceptible”が削除 → MIC ≦ 4μg/mLをSDD (Susceptible-Dose Dependent) と設定1) • , EUCASTではエビデンス不 分としてbreakpointの設定はなし2) 十 門 1. Clin Infect Dis. 2020;70:1240-1246. 2. Clin Microbiol Infect. 2020;26:1039-1043. 方 一 DAPのbreakpoint (CLSI)
#39.
E. faeciumにおけるDAP耐性 • liaFSR (細胞膜のストレス応答を調節するシステム) の変異がDAP-Rに関連し1), 応答調 節因 LiaRを 失させると, DAP-Rがhypersusceptibilityへ逆転する2) • E. faeciumのMIC≦2mg/dLならliaFSR変異は存在しなかったが, 3-4mg/dLの株におい て 率に存在1) 1. Antimicrob Agents Chemother. 2012;56(8):4354-4359. 欠 子 高 2. Antimicrob Agents Chemother. 2015;59(12):7327-7334.
#40.
E. faeciumにおけるDAP耐性 • LiaFSRシグナル経路に変異を有するE. faeciumはDAP存在下で早期に耐性化する が, LiaRを 失させても中 期的曝露で MICが上昇する1) • cls (細胞膜構造調節)2), dltABCD/mprF (細 胞表 膜電位の上昇)3), divIVA/oatA (バ イオフィルム形成)3)もDAP耐性に関連 長 欠 面 1. Antimicrob Agents Chemother. 2021;65(4):e01317-20. 2. J Antimicrob Chemother. 2016;71(10):2793-2797. 3. Antimicrob Agents Chemother. 2019;63(10):e00790-19.
#41.
E. faecalisにおけるDAP耐性 • E. faecalisではDAP耐性に関与する3つの機構がある • LiaFの177位に存在するイソロイシンの単 の殺菌活性が低下する1) • 他に, リン脂質代謝に関与する2因 の変異が関係する; グリセロール-ホスホジエステ ラーゼをコードするgpdD, カルジオリピンシンターゼをコードするcls2-3) 失により, MIC 1→4μg/mlに増加し, DAP 欠 一 子 1. Antimicrob Agents Chemother. 2013;57(6):2831-2833. 2. N Engl J Med. 2011;365(10):892-900. 3. Antimicrob Agents Chemother. 2011;55(7):3345-3356.
#42.
DAPのポジション • DAP MIC 2-4 mg/LのE. faeciumに対し, DAP 10-12mg/kgならfAUC/MIC≧27.4を達成可能1) • VRE患者の予後を評価した後 視的研究では, DAP 8-10mg/kgが6mg/kgよりも予後・微 物学的治療成 2), MIC 4mg/LのE. faecium菌 功率が かった 症をDAPで治療すると再燃が多く, DAP ≧8mg/kg でも転機に関与しない可能性がある3) • DAP 10-12mg/kgでも, E. faecalis (MIC 4mg/L) およびE. faecium (MIC 4-8mg/L) による感染症を治 療することはPK-PDデータからは難しい可能性がある4) • VREによる感染性 内膜炎のマウスモデル研究では, DAP 12mg/kgはMIC 0.5 mg/Lと8 mg/Lの両 クリアランスを めたが, MIC 8 mg/Lでは疣贅を無菌化できなかった5) 症に対するDAPは12mg/kgが望ましく, IEなどの侵襲性感染症に対しては慎重に使 する 用 方 Clin Infect Dis. 2019;68:1650-1657. Clin Infect Dis. 2017;64:605-613. Clin Infect Dis. 2016;62(12):1514-1520. Clin Microbiol Infect. 2020;26(8):1039-1043. Microbiol Spectr. 2022;10(5):e0255122. 生 血 1. 2. 3. 4. 5. 方 方 心 血 一 高 高 → E. faecium菌 べきである で
腸球菌に対するフルオロキノロンとアミノグリコシドの使用
#43.
DAP vs オキサゾリジノン • PS matchを • VRE菌 症患者に対するDAP vs LZDを評価したメタ解析では, DAP群で死亡率上昇 (OR 1.41) したが2), DAP 6mg/kgでありunder dose → E. faecium菌 • いた観察研究で, E. faecium菌 症ではLZD≧DAPだが, 症に対してVCM=LZD1) 量DAPとLZDの 較試験が望まれる。 同じオキサゾリジノンであるTZDも感性を有するが使 例は少ない3) 比 用 血 用 高 fi 血 用 血 1. Int J Antimicrob Agents. 2019;54(5):572-578. 2. Antimicrob Agents Chemother. 2014;58(2):734-9. 3. Open Forum Infectious Diseases, Volume 3, Issue suppl_1, December 2016, 1344, https://doi.org/10.1093/o d/ofw172.1047
#44.
• 23S rRNA変異 (リボゾーム結合部位に関与) がオキサゾリジノン耐性の主なメカニズム で, 変異にまつわる責任遺伝 はプラスミド由来のcfrで, IS256の挿 によって付与され る (Staphylococcus spp.も)1) • optrA, poxtAにより23S rRNA変異 (保護) が optrA, poxtAはTZD耐性も来たす2) • 上記変異を持たない場合, rRNAのG2573T変異やリボゾーム蛋 のrplC (L3)及びrplD (L4) 変異がLZD耐性に関与しうる3) • agar-dilution methodでは2 間 (>42時間) 待って結果を判定し, いる場合はtrailingによる偽耐性に注意する4) じ, cfrがLZDのみ耐性となる , 動感受性測定器を 方 Expert Rev Anti Infect Ther. 2014;12(10):1221-1236. J Clin Microbiol. 2022;60(9):e0084321. Drug Resist Updat. 2018;40:25-39. J Antimicrob Chemother. 2020;75(9):2587-2593. 一 入 自 白 生 日 1. 2. 3. 4. 子 用 オキサゾリジノン耐性
#45.
イミペネムは使ってもいいのか? • PCG-S E. faecalisに対して, IPMはPCGと同等の活性が期待できるが, 殺菌的ではない • βラクタマーゼ以外の機序によるPCG-Rの場合はIPMも耐性化する • IPMとAGのシナジーは, E. faecalis IEの治療において得られない → ペニシリン系抗菌薬との 較試験はないものの, E. faecalisを治療する を使 することはない (複数菌感染で検討することはある) 的であえてIPM 目 比 用 M. Lindsay Grayson, Kucers' The Use of Antibiotics 7th ed. sec.37
#46.
フルオロキノロン (FQs) • 標的部位変異1)→gyrA, parCを介して抗菌薬との結合親和性を変化させる - E. faeciumとE. faecalisでの報告はあるが, E. gallinarumとE. casseli avusにはない • 排出ポンプ2)→NorA - NorAとPmrAは でも認められる • 標的部位保護3)→qnrによって媒介される (E. faecalis) - 腸内細菌科で われるPMQRに似た 連のペンタペプチド反復を持つタンパク - FQsのDNA結合とそれに続くキノロン-ジャイレース複合体の形成を減少させる MFLXでE. faecalisの慢性前 腺炎を治療した報告はあるが4), 原則単剤では 用 fl 一 立 色 黄 1. 2. 3. 4. 5. 言 • ブドウ球菌と肺炎球菌のキノロン耐性に関係し, 前者はE. faecium いない5) J Chemother. 2011;23(2):87-91. J Antimicrob Chemother. 2003;51 Suppl 1:29-35. Antimicrob Agents Chemother. 2005;49(1):118-125. J Infect. 2008;56(2):155-156. Clin Microbiol Infect. 2010;16(6):555-562.
#47.
TMP/SMX • ほとんどの細菌は外因性の葉酸を環境から取り込むことができないため, 葉酸合成経路を 有する • TMP/SMXは, ジヒドロ葉酸の • Enterococcus spp.はin vitroでTMP/SMXに感受性を すが, Enterococcus spp.は外因 性の葉酸を利 できるため, in vivoでは無効 (標的部位がバイパスされる) 成とそれに続くテトラヒドロ葉酸の合成を阻害する 示 生 用 Expert Rev Anti Infect Ther. 2014;12(10):1221-1236.
#48.
アミノグリコシド (AGs) lEnterococci display intrinsic tolerance (manifested by the lack of bactericidal activity) to the aminoglycosides. This phenomenon seems to • 主に2つの機序によって, Enterococcus spp.はAGsに対して内因性耐性を有する - 透過性低下 ( 濃度ならば細胞内へ侵 可能) 固有のアミノグリコシド修飾酵素 (AME) による構造変化 • 染 体性にAAC(6′)-Ii (TOB, KM etc), APH(3′)-IIIa (AMK etc)といったAMEを有し, さ らに16S RMTases (EfmM) を介したリボゾーム修飾を起こす場合もある • GMとSMはAMEによる影響を受けにくいため, GM≦500μg/ml, SM≦2000μg/mlならば シナジーが期待できる - aac(6′)-Ie–aph(2″)-IaによりGM 濃度耐性, リボゾーム変異またはstreptomycinnucleotidyltransferase enzymeによってSM 濃度耐性が付与される 高 入 高 高 色 Expert Rev Anti Infect Ther. 2014;12(10):1221-1236.
感染性内膜炎における腸球菌の治療方針
#49.
テトラサイクリン (TCs) • リボゾームに結合してアミノアシルtRNAの結合を可逆的に妨害することで静菌的な抗菌 作 を有する • 薬剤耐性は主に2つの機序による1) • - 排出ポンプ:plasmid由来の因 であるtetKとtetLによりcodeされる排出ポンプは, “テトラサイクリン”耐性となるがMINOは耐性化しない - リボゾーム保護:染 体由来の因 であるtetM, tetO, tetSは, “テトラサイクリン”以 外にDOXYとMINOをも耐性化し, Tn916を介して伝達される (TGCは耐性化しない) TCsによる単剤治療は推奨されず, VREなどで代替薬がない場合に検討される併 つという位置付け2) 薬の 一 用 子 子 色 用 1. Expert Rev Anti Infect Ther. 2014;12(10):1221-1236. 2. Clin Microbiol Infect. 2010;16(6):555-562.
#50.
チゲサイクリン (TGC) • VCM感受性E. faecalisによるSSTIにおいて, TGCの治癒率 87.5% (ただしnは少ない)1) • VCM感受性E. faecalisを含む複雑性腹腔感染症に対し, TGCはIPMと同等の治癒率 (78.8%)2) • TGC単剤療法の問題点として, 得られる 菌が出現することが報告されている4) → 重症腸球菌感染症に対して単剤で 中濃度が低いことが挙げられ3), 治療中に耐性 いることは不適切 1. Clin Infect Dis. 2005;41 Suppl 5:S341-S353. 2. Clin Infect Dis. 2005;41 Suppl 5:S354-S367. 3. J Antimicrob Chemother. 2007;59(1):128-131. 血 用 4. Antimicrob Agents Chemother. 2003;47(1):216-222.
#51.
概論 • 菌 • 治療と薬剤耐性 (総論, 各論) • IEに対する抗菌薬併 について 症 用 血 •
#52.
感染性 内膜炎 (E. faecalis) • Enterococcus spp.によるIEの90%1) • NVEとPVEで, 抗菌薬選択に違いはない (PVEは6週間治療) • 治療薬と期間:ABPC 12g + GM 3mg/kg or CTRX 4g 6週間 - GMは, 濃度耐性 (MIC>500μg/mL) がなければ, 3mg/kg q24h or 1mg/kg q8h2-3)を 2-6週間併 する - 症状持続期間が≦3ヶ ならば治療期間は4週間でよいとAHAに記載されているが3), 6週間 の が再燃が少ない可能性があり4), ESCでは6週間治療が推奨されている2) 月 心 用 高 方 1. 2. 3. 4. Clin Microbiol Infect. 2013;19(12):1140-1147 Eur Heart J. 2023;44(39):3948-4042. Circulation. 2015;132(15):1435-1486.. PLoS One. 2018;13(2):e0192387.
#53.
感染性 内膜炎 (E. faecium) • Enterococcus spp.によるIEの5%1) • 抗菌薬選択と期間:VCM + GM 6週間2-3) • VREの場合, AHAではLZD 1200mg or DAP 10-12mg/kgが推奨されている3)が, ESCで はDAP 10-12mg/kg+βL (ABPC, EPM, or CFT) or FOSが推奨されている2) - ABPCは膜表 の陽性荷電を減少させることで, DAPのMICを低下させ殺菌効果を ることがin vitroで報告されている4) Clin Microbiol Infect. 2013;19(12):1140-1147 Eur Heart J. 2023;44(39):3948-4042. Circulation. 2015;132(15):1435-1486. Antimicrob Agents Chemother. 2012;56(2):838-844. 高 心 面 1. 2. 3. 4. め
#54.
併 • 薬としてのCTRX ABPCは, E. faecalisのPBP4およびPBP5を部分的に飽和させるが, 細胞壁合成に関与する PBP2およびPBP3を飽和させることはできない → PBP2およびPBP3に結合できるセファロスポリン系抗菌薬を併 することで, シナジー効 果が得られる1) • PRASでは, PBP2変異の有無に関わらずABPC+CTRXにシナジーを有さない2) • CTRX-MIC ≧ 512μg/mLの場合は, ABPCとの併 • E. faeciumではPBP5の過剰産 や変異によりABPCの感受性が低下しており4), この効果 は確認されていない5) でシナジーがない3) 1. Antimicrob Agents Chemother. 1995;39:1984-1987. 2. Antimicrob Agents Chemother. 2023;67(2):e0087122. 用 用 生 用 3. Microbiol Spectr. 2022;10(4):e0062122. 4. J Clin Microbiol. 2019;57(3):e01467-18. 5. J Antimicrob Chemother. 2019;74(8):2269-2273.
#55.
• 少なくともCCr<50ml/minではGMを避ける1) • いくつかの観察研究で, ABPCとCTRXの併 • 個 だが, 有害事象が少ないことが は, AGとの併 と 較し, 再燃率・死亡率は同等 されている2-4) 的には, CTRXをGMに優先して使 することがほとんどである 比 の変化に注意6) 用 見 - eGFR<60は胆泥形成リスクであり, 腹部所 用 CTRXが肝胆道系酵素上昇などで継続できない場合, 臨床データは乏しいがCTXへの変更を 考慮する5) 用 - 示 人 AGなのかCTRXなのか 1. 2. 3. 4. 5. 6. Circulation. 2015;132(15):1435-1486.. J Clin Med. 2021;10(19):4594. Clin Infect Dis. 2023;76(2):281-290. Clin Infect Dis. 2024;79(5):1162-1171. Antimicrob Agents Chemother. 1995;39:1984-1987. Clin Exp Nephrol. 2018;22(3):613-619.
腸球菌感染症の症例報告と治療経過
#56.
そもそも併 しなければいけないのか? • 1950年代より, PCNとAGsの併 によりin vitroでsynergyがあることが報告されており1), 動物モデルの研究では弁に付着する細菌量を減らす効果が確認されている2) • Enterococcal IE 33名のうち, 治療失敗がPCN単剤群 61% (11/18) に対してSM併 14% (2/12) と併 群で少ない傾向にあった3) • 併 薬ごとのE. faecalis IE再燃リスクについて評価した研究でも, ABPC群は9名と少 数で評価が難しい4) • 歴史的に広く いられている併 療法だが, 規模な観察研究やRCTで効果が確認されてい るわけではなく, 単剤治療をpreferred therapyとしている報告もある5) 較として置かれた Am J Med. 1950;8(4):532. Antimicrob Agents Chemother. 1986;30(5):725-728. Circulation. 1954;10(2):173-194. Clin Infect Dis. 2023;76(2):281-290. JAMA Netw Open. 2023;6(7):e2326366. 用 比 大 用 用 用 人 用 用 1. 2. 3. 4. 5. 用 群
#57.
• Enterococcal IEは術前2週間以上抗菌薬治療を い1) • E. faecalis IEに対して術前6週間以上の治療の後に採取した疣贅培養が2/8 ABPC+CTRXでも+GMでも, 6〜12ヶ なっても疣贅培養陽性率が他細菌より で陽性2) 後再燃率が10%前後 ただし, NVEかPVEか, 治療内容など詳細不明 少なくともEnterococcal PVEは保存的加療による再燃が他細菌より多い3) →Enterococcal IEはopeの閾値を下げた がいいかもしれない 1. J Am Coll Cardiol. 2020;76(1):31-40. 行 方 2. Clin Infect Dis. 2023;76(2):281-290. 3. Clin Infect Dis. 2020;71(5):1316-1319. 人 • - 月 高 Enterococcal IEは難治性
#58.
複雑性菌 感染性 症 内膜炎 E. faecalis E. faecium ABPC 代替薬: ・混合感染の場合:PIPC, IPM ・アレルギーの場合:VCM, DAP, LZD VCM 代替薬:DAP, LZD ABPC+CTRX or ABPC+GM 代替薬: VCM+GM, TEIC, DAP+BLs VCM+GM 代替薬: DAP+GM, LZD, DAP+BLs Clin Microbiol Infect. 2021;27(3):364-371.より作成 用 用 血 *DAP+BLs併 によりシナジーがin vitroで確認されているが臨床的に有意義かは 不明であり, ABPCやVCMが使 できない状況でのみ検討 心 非 治療のまとめ① J Antimicrob Chemother. 2015;70(6):1738-1743.
#59.
治療のまとめ② 平たくいうと - ABPC-S Enterococcus → ABPC 8-12g/day - ABPC-R Enterococcus → ペニシリナーゼ由来ならA/S, PBP由来ならVCM - 上記に, focus, 菌種次第でGMやCTRXを併 用 • する
#60.
感染巣 原発性 管内デバイス 腹腔 殖器・尿路 SSTI 症の特徴まとめ Rate (%) All E. faecalis E. faecium 22 23 20 15 17 10 41 30 61 27 5 36 5 9 6 IE risk エコー source control 培フォロー 抗菌薬 治療期間 必須 ー 必須 併 2-6週間 中 推奨 推奨 必須 単剤 2-4週間 低 推奨 推奨 推奨 広域 1-4週間 推奨 カテーテル関 連なら推奨 推奨 単剤 1-2週間 推奨 膿瘍などあれ ば推奨 推奨 単剤 1-2週間 低 低 血 Clin Microbiol Infect. 2021;27(3):364-371.より作成 用 高 血 心 生 血 菌
#61.
腹腔や尿路にentryはなく, E. faecalis菌 • 経胸壁 • 治療開始2 • 経 • ABPC 2g*q4h+CTRX 2g*q12hへ変更 • A弁再置換術を • 6週間治療を われた 症に対しABPC 2g*q6h開始 エコーでは著変なし 後の 液培養でもE. faecalisが発育 エコーでA弁に10mmの疣贅あり われ, 術中検体の培養からもE. faecalis 血 血 道 行 行 • 日 心 心 食 CASE ①
腸球菌感染症の治療におけるケーススタディ
#62.
液培養は陰性だったが, 腹 培養からE. faecium, E. faecalis, E. coli, B. fragilis, Clostridium spp., F. nucleatumが発育 • ショック状態が続いており, POD2よりVCMを追加 • 以降徐々にカテコラミンを減量でき, POD6にCTRX+Metro+VCMへde-escalation • 遺残膿瘍あり, 計4週間治療を 行 • 水 血 CASE ② った
#63.